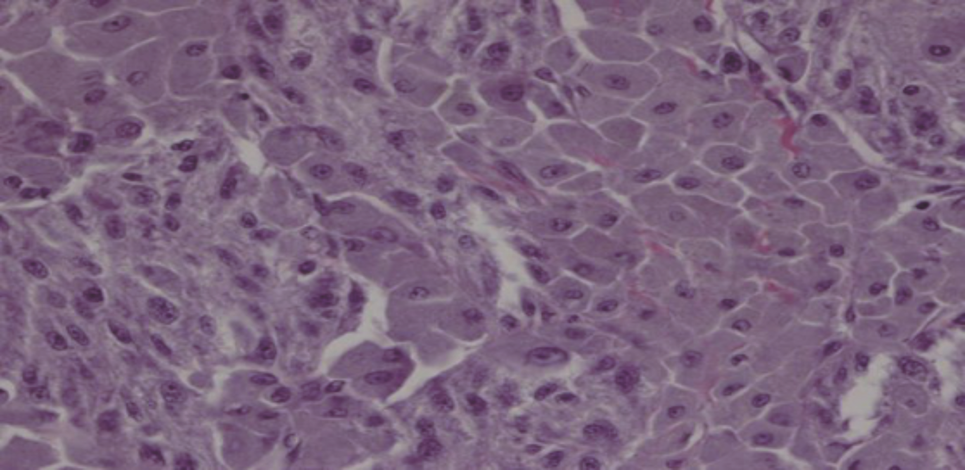

患者,女性,46岁。因右侧头面部无汗及右侧眼睑下垂7年,半年前发现右上颈肿物入院。
肿瘤大小约4 cm×3 cm,质地韧,可横向活动,纵向活动差,未闻及杂音,未触及震颤。综合患者病史和影像学表现,临床倾向于右上颈神经鞘瘤,来自交感神经。
超声提示甲状腺结节,倾向恶性。
于2021年8月20日行右上颈部肿物切除术+甲状腺全切+右6区淋巴结清扫术。术中探查见右上颈5 cm×4 cm×3 cm肿物,似有包膜,呈黑色椭圆形,遂完整切除肿瘤。术后病理考虑黑色素性神经鞘瘤,甲状腺右叶乳头状癌。
综合术后免疫组化结果,未给予患者术后辅助治疗,建议患者定期随访观察。
肿瘤科;头颈外科

版权归中华医学会所有。本文为遵循CC-BY-NC-ND协议的开放获取文章。
黑色素性神经鞘瘤(melanotic schwannoma, MS)是一种罕见的神经鞘瘤,其发生率不足神经鞘瘤的1%[1]。MS常常单发,偶见多发,发病年龄大多为30~40岁,男女发病比例相似[2]。自1932年首次报道以来[3],关于MS的文献大多为病案报道,且国内报道不足30篇,国外报道不足200篇,在临床诊疗中容易误诊,因此引起临床医师的重视。现报道一例颈交感神经来源的MS,并复习相关文献,以提高临床诊治经验。
患者,女性,46岁,7年前无明显诱因出现右侧头面部无汗,伴右侧眼睑下垂,症状间断出现,与活动和休息后无明显关联。否认视物模糊、重影等症状,否认声音嘶哑、放射性耳痛和吞咽不协调,否认舌活动障碍,未引起重视。半年前检查发现右侧颈部肿物,于2021年8月来院诊治。
入院时查体:颈软,颈部可见5 cm横行瘢痕。右侧上颈部可及一肿物,约4 cm×3 cm,质地韧,表面光滑,可横向活动,纵向活动差未闻及杂音,未触及震颤。既往史:患者7年前因甲状腺肿物曾在外院行手术治疗,病理为结节性甲状腺肿,术后定期复查;患者高血压病史5年,自诉血压控制尚可。患者否认冠心病、糖尿病、心房黏液瘤和库欣综合征等病史。家族史:哥哥为甲状腺肿瘤患者。增强CT:右侧颈动脉鞘间隙可见一实性肿物(图1),形态欠规则,边界尚清,大小约3.5 cm×2.6 cm,增强扫描明显不均匀强化,颈内外动脉分离;提示右颈鞘肿物,倾向颈动脉体瘤。超声:甲状腺右残叶中部内侧见一个低回声结节,大小0.8 cm×0.7 cm,边界不清,左侧残叶上极内侧见一低回声结节,大小0.6 cm×0.3 cm,边界尚清;右侧中上颈颈鞘深面见一个实性肿物,大小约3.5 cm×3.5 cm(图2),向前推压至颈鞘,致颈内、外动脉夹角增大,形态欠规则,边界尚清。提示:甲状腺右叶残叶实性结节,炎性与癌待鉴别;甲状腺左叶残叶结节,良性;右颈中上颈实性肿物,良性,符合神经源肿瘤。心电图、胸部CT扫描及实验室检查未见明确异常。




患者发现颈部肿物半年并伴有典型霍纳综合征表现,体格检查肿物可横向活动,纵向活动差,未闻及杂音,未触及震颤。CT提示颈内外动脉分离,倾向颈动脉体瘤,但超声提示向前推压肿物至颈鞘,致颈内、外动脉夹角增大。综合患者病史及影像学表现,临床倾向于右上颈神经鞘瘤,来自交感神经。术前诊断:颈部神经鞘瘤,甲状腺结节(外院术后复发,不除外恶性),颈交感神经麻痹(霍纳综合征)。
2021年8月20日患者在充分术前准备后全麻下行右上颈部肿物切除术+甲状腺全切+右6区淋巴结清扫术。首先行右上颈肿物切除,术中探查可见右上颈肿物,大小约5 cm×4 cm×3 cm,似有包膜,呈黑色椭圆形;位于颈总动脉分叉、颈内外动脉后方,上界接近颅底,下界达颈总动脉分叉,将颈内静脉向后推移,与颈内动脉轻度粘连,可锐性分开,颈内动脉部分嵌入肿瘤,形成凹陷;肿物与迷走神经粘连,下端增粗,上段难以解剖。分开颈内动静脉,从颈鞘间入路沿肿瘤包膜逐层分离肿物,迷走神经被包裹无法保留遂于肿瘤上下两极切断,游离颈总动脉和颈内外动脉,切除肿瘤。右上颈肿物切除后探查甲状腺,在快速病理证实甲状腺右叶结节为甲状腺乳头状癌,行完成甲状腺全切除及右中央区淋巴结清扫。术后肉眼可见灰红灰黑色结节1枚,大小约6.5 cm×4.5 cm×1.9 cm,上附包膜,包膜完整,沿最大面切开,切面灰黑质韧,局灶灰白。术后病理:考虑色素性神经鞘瘤。低倍镜下,可见大量色素弥漫分布,覆盖肿瘤细胞,肿瘤细胞巢周围可见神经分布。高倍镜下,于色素间可见散在分布的肿瘤细胞,呈圆形、卵圆形或短梭形(图3)。经脱黑色素处理后,可见肿瘤细胞呈实性巢片样分布,其间可见散在分布的玻璃样变纤维组织;肿瘤细胞呈多边形,铺路石样/镶嵌样,细胞质丰富,肿瘤细胞核呈空泡样,核膜清楚,部分核膜皱缩不规则,可见小核仁,未见核分裂象(图4)。病理报告甲状腺右叶乳头状癌,甲状腺左叶结节性甲状腺肿伴腺瘤样增生,淋巴结可见转移癌(2/5),pT1aN1a期。免疫组化:AE1/AE3(-),HMB-45(-),Ki-67(+)<1%,MELAN-A(-),MelanomaPan(-),S-100(+),Vimentin(+)。分子病理:未发现PRKAR1A、RET、BRCA1、MLH1、MLH2及其他同源重组修复基因胚系致病突变。术后诊断:颈部MS,甲状腺乳头状癌pT1aN1a期,颈交感神经麻痹(霍纳综合征)。




建议患者术后3个月复查,目前患者术后积极随访。
MS是一种罕见的,具有双向分化潜能的以分泌黑色素为特征的神经鞘瘤。其起源于施旺细胞,好发于脊神经根及交感神经干,以脊髓硬膜下常见,罕见位于脊髓内,也可发生于躯干和四肢[4]。MS的临床表现往往取决于肿瘤发生位置和生长速度[5, 6]。可分为砂粒体型和经典型,砂粒体型和经典型的临床病理特征相似,砂粒体型MS发生率约为10%~40%[7],其中患者可伴有颜面部皮肤色素沉着,心脏黏液瘤及内分泌功能亢进,称为Carney综合征(Carney Complex,CNC)。有研究显示,在高达50%的CNC中与砂粒体型MS相关[8]。CNC作为一种常染色体显性遗传疾病,于1985年首次报道,目前研究认为,17号染色体上的长臂基因PRKAR1A基因与CNC的发病有关[9],因此我们也有理由推测,MS的发病机制与PRKAR1A基因存在一定的联系。CNC的临床表现复杂多样、个体化差异明显,常常伴有睾丸肿瘤、甲状腺肿瘤、MS、乳腺导管腺瘤、骨软骨黏液瘤等。目前公认的CNC诊断标准为:(1)符合CNC主要临床特征中的2项或2项以上;(2)有PRKAR1A基因突变或一级亲属中有CNC患者,同时符合1项或1项以上主要临床特征[8]。然而,目前对于CNC患者及PRKAR1A基因携带者尚无优选的治疗方案,大多数研究建议在治疗伴发疾病的基础上进行至少1年1次的积极随访[8]。本例患者同时合并甲状腺乳头状癌、MS,但分子病理结果提示,未发现PRKAR1A基因突变,因此暂不考虑卡尼综合征的诊断。
MS肿瘤内含有大量黑色素颗粒,黑色素中的稳定自由基团在磁场中呈顺磁性,减少核磁中T1、T2的弛豫时间,表现出T1WI高信号,T2WI极低信号[10]。因此核磁(MRI)常常作为诊断MS的首选影像学检查,尤其是对于椎管内的MS。相比之下,CT对于椎管外MS可起到一定的诊断作用。遗憾的是,本例患者术前行CT和超声检查,综合诊断为神经鞘瘤,未行磁共振检查。我们认为,对于椎管外MS,术前高水平超声及多元化检查为MS的术前诊断可提供一定帮助,尤其是磁共振检查对术前诊断可起到极为重要的作用。
MS在影像学中由于邻近颈动脉窦和血管,术前常被误诊为颈动脉体瘤。其术中快速病理及术中所见常常引起临床医师对MS的关注。然而对于MS的诊断,术后免疫组化分析、网状蛋白染色以及与颈交感神经的相互关系至关重要。大多数MS病灶直径>5 cm,切面为柏油样黑色。镜下MS表现为梭形、上皮样细胞,胞质内可见含量不等的色素,其银染呈阳性,PAS染色呈阴性。MS免疫组化结果在不同报道中结果不尽相同,但多数S-100,HMB-45呈阳性[5,11]。但也有研究显示,MS和黑色素瘤都可能表达S-100或其他黑色素细胞标志物,网状蛋白染色在区分MS和黑色素瘤方面非常有效[7]。MS生物学行为具有恶性潜能,后续生物学行为往往难以估计,可发生术后局部复发、浸润周围组织及远处转移,但后两种较为罕见。目前为止,全球对于MS的报道不足200例,Torres-Mora等[12]对40例恶性MS患者进行了统计,发现局部复发率及疾病特异性死亡率分别为35%和27%,42%的患者发生远处转移,并且累及肺、肝、脑、骨。恶性MS的复发和转移较快,而非恶性MS复发时间大约为4~5年后。在以往的研究中,MS大多数临床上被认为良性肿瘤,但由于MS具有恶性潜能,因此对于MS的综合治疗以及随访仍然是不可忽视的。考虑到患者有复发和转移的倾向,许多学者认为MS应当被当作恶性肿瘤诊治[13]。但并不是所有的MS患者均接受术后放疗或辅助治疗,目前的个案报道也未详细描述术后治疗方案及术后生存时间。当局部浸润不能完全切除肿瘤时以及术后免疫组化提示分化较低且恶性潜能较高,建议辅助放疗,以防止局部复发和转移[14, 15, 16, 17]。本例患者免疫组化结果提示,S-100与Vimentin阳性,考虑为神经来源,但其余结果显示为阴性,且Ki-67<1%,与以往报道的免疫组化结果有一定的差异,因此我们认为,其MS恶性潜能较低,未给予术后辅助治疗,建议患者定期随访观察。
综上,MS术前诊断难,往往术中探查时才引起重视,因此若颈部神经鞘瘤合并其他肿瘤时,应考虑MS的可能性。目前MS的治疗尚无标准的治疗指南,手术是主要的治疗措施,放射治疗、免疫治疗、药物治疗等的治疗效果也无明确的结果。因此,彻底的手术切除、重视周围解剖结构的保护是避免肿瘤局部复发和保留功能的有效治疗方式。
所有作者均声明本研究不存在利益冲突